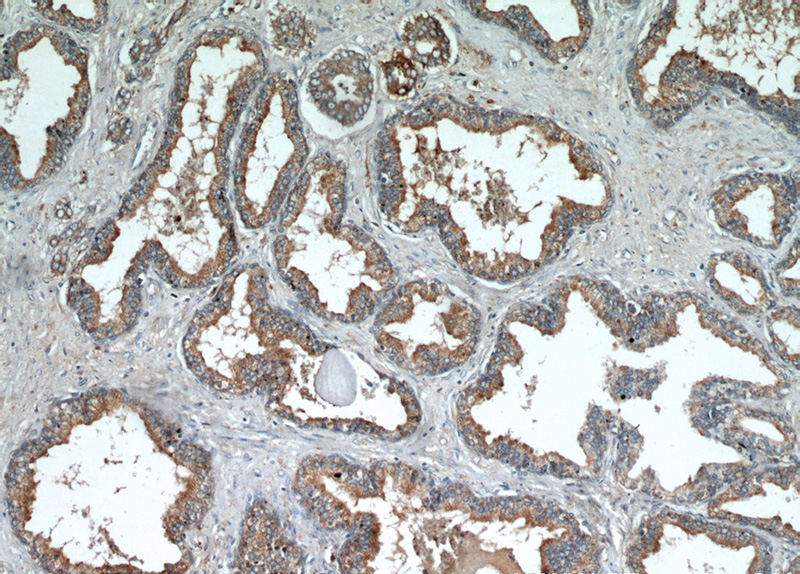
Immunohistochemical of paraffin-embedded human prostate hyperplasia using Catalog No:112197(LEPR antibody) at dilution of 1:50 (under 10x lens)
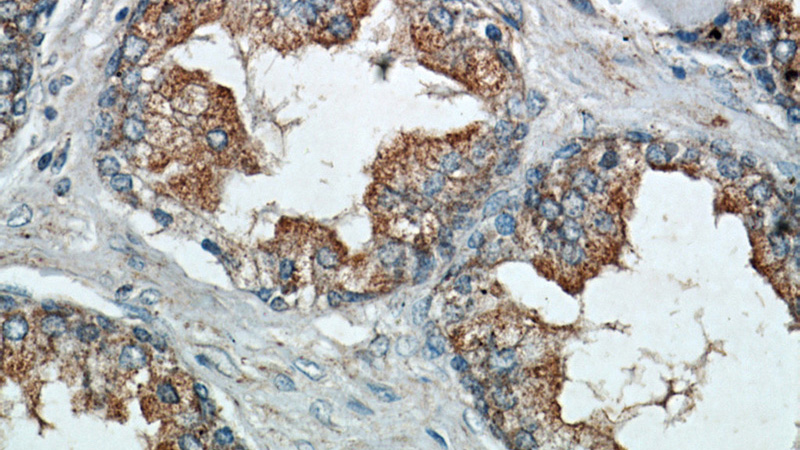
Immunohistochemical of paraffin-embedded human prostate hyperplasia using Catalog No:112197(LEPR antibody) at dilution of 1:50 (under 40x lens)

-
Product Name
LEPR antibody
- Documents
-
Description
LEPR Rabbit Polyclonal antibody. Positive FC detected in HeLa cells. Positive IF detected in MCF-7 cells. Positive IHC detected in human prostate hyperplasia tissue, human heart tissue. Positive IP detected in mouse heart tissue. Positive WB detected in mouse heart tissue, PC-3 cells. Observed molecular weight by Western-blot: 150 kDa
-
Tested applications
ELISA, IHC, IF, WB, IP, FC
-
Species reactivity
Human, Mouse; other species not tested.
-
Alternative names
CD295 antibody; HuB219 antibody; LEP R antibody; LEPR antibody; leptin receptor antibody; OB R antibody; OB receptor antibody; OBR antibody
-
Isotype
Rabbit IgG
-
Preparation
This antibody was obtained by immunization of Peptide (Accession Number: NM_002303). Purification method: Antigen affinity purified.
-
Clonality
Polyclonal
-
Formulation
PBS with 0.02% sodium azide and 50% glycerol pH 7.3.
-
Storage instructions
Store at -20℃. DO NOT ALIQUOT
-
Applications
Recommended Dilution:
WB: 1:500-1:5000
IP: 1:200-1:2000
IHC: 1:20-1:200
IF: 1:10-1:100
-
Validations

mouse heart tissue were subjected to SDS PAGE followed by western blot with Catalog No:112197(LEPR Antibody) at dilution of 1:1000
Immunohistochemical of paraffin-embedded human prostate hyperplasia using Catalog No:112197(LEPR antibody) at dilution of 1:50 (under 10x lens)
Immunohistochemical of paraffin-embedded human prostate hyperplasia using Catalog No:112197(LEPR antibody) at dilution of 1:50 (under 40x lens)

IP Result of anti-LEPR (IP:Catalog No:112197, 5ug; Detection:Catalog No:112197 1:700) with mouse heart tissue lysate 4000ug.

Immunofluorescent analysis of MCF-7 cells using Catalog No:112197(LEPR Antibody) at dilution of 1:25 and Rhodamine-Goat anti-Rabbit IgG

1X10^6 HeLa cells were stained with 0.2ug LEPR antibody (Catalog No:112197, red) and control antibody (blue). Fixed with 4% PFA blocked with 3% BSA (30 min). Alexa Fluor 488-congugated AffiniPure Goat Anti-Rabbit IgG(H+L) with dilution 1:1500.
-
Background
The hormone leptin, secreted predominantly from adipose tissue, plays a crucial role in the regulation of numerous neuroendocrine functions, from energy homeostasis to reproduction (PMID: 22249808). Leptin acts through the leptin receptor (LEPR, also known as OB-R), a single-transmembrane-domain receptor of the cytokine receptor family. On ligand binding, LEPR mediates signaling through JAK2/STAT3 (PMID: 9102398). LEPR plays an important role in the regulation of glucose homeostasis via feeding and adiposity. Alternatively spliced transcript variants encoding different isoforms of LEPR have been described. This antibody can recognize long (LEPRb) and short (LEPRa,c,d) isoforms.
-
References
- Fan Y, Gan Y, Shen Y. Leptin signaling enhances cell invasion and promotes the metastasis of human pancreatic cancer via increasing MMP-13 production. Oncotarget. 6(18):16120-34. 2015.
Related Products / Services
Please note: All products are "FOR RESEARCH USE ONLY AND ARE NOT INTENDED FOR DIAGNOSTIC OR THERAPEUTIC USE"
